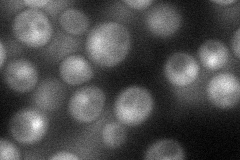
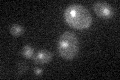

View description
Actin-related protein that binds nucleosomes; a component of the SWR1 complex, which exchanges histone variant H2AZ (Htz1p) for chromatin-bound histone H2A
Localization:
Intensity:
Fold change:
Significance:
-
C’ GFP library in SD

nucleus17.86 -
N' NOP1pr-GFP in SD
punctate,nucleus59.1863 -
N' TEF2pr-mCherry in SD

punctate,nucleus13.9555 -
N' NATIVEpr-GFP in SD

punctate,nucleus20.2056 -
N' TEF2pr-VC and Cyto-VN in SD

below threshold29.1874 -
C’ GFP library in SD+DTT

nucleus18.791.05No -
C’ GFP library in SD+H2O2

nucleus19.041.06No -
C’ GFP library in Starvation Media
nucleus17.080.95No -
C’ GFP library on the background of Pup2-DaMP

nucleus -
C’ GFP library on the background of CCT mutant

nucleus17.43250.975384No
